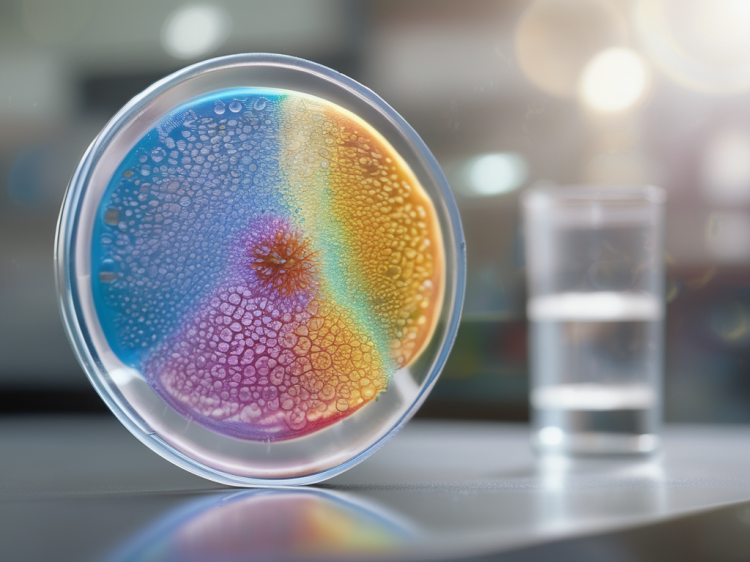

Hormonlar, hormonlar…
Her yerde önemlidirler ve kontrol etmedikleri neredeyse hiçbir şey yoktur!
Özellikle sindirim ve bağırsak sağlığı. Bağırsak sağlığı olmadan iyi bir fiziksel ve zihinsel sağlık mümkün değildir.
1. Gastrointestinal hormonlar

Sindirim sisteminin kendisi, sindirimi ve bağırsak hareketini düzenleyen çeşitli hormonlar üretir:
- Gastrin: Yiyeceklerin sindirilmesi için gerekli olan mide asidinin üretimini uyarır.
- Sekretin: Mide asidini nötralize etmek için pankreastan bikarbonat salınımını teşvik eder.
- Kolesistokinin (CCK): Pankreastan sindirim enzimlerinin ve safra kesesinden safranın salınmasını uyarır.
- Motilin: Bağırsak hareketini düzenler ve mide-bağırsak kanalında “ev temizliği hareketliliği” denilen şeyi sağlar.
2. Cinsiyet hormonlarının etkisi

Östrojen ve progesteron gibi seks hormonları da bağırsak fonksiyonunu etkileyebilir:
- Östrojen: Adet döngüsü veya hamilelik sırasında ortaya çıkan yüksek östrojen seviyeleri bağırsak hareketini yavaşlatabilir ve kabızlığa yol açabilir. Öte yandan menopoz sırasında östrojenin azalması bağırsak hareketlerini hızlandırıp ishale yol açabilir.
- Progesteron: Özellikle hamilelik sırasında artan progesteron seviyeleri bağırsak kaslarını gevşetebilir ve peristaltizmi yavaşlatarak kabızlığa yol açabilir.
3. Stres hormonları
Kortizol ve adrenalin gibi stres hormonları da bağırsak fonksiyonunu etkiler:
- Kortizol: Kronik olarak yüksek kortizol seviyeleri bağırsak bariyerini zayıflatabilir, iltihaplanmayı teşvik edebilir ve bağırsak florasını olumsuz yönde etkileyebilir.
- Adrenalin: Akut stres sırasında adrenalin bağırsak hareketini engelleyebilir ve sindirim sistemine giden kan akışını azaltarak hazımsızlığa neden olabilir.
4. Hormonal bozukluklar ve bağırsaklar
Hormonal dengeyi etkileyen hastalıklar bağırsakları da etkileyebilir:
- Tiroid bozuklukları: Hipotiroidizm (az çalışan tiroid) bağırsak hareketlerinin yavaşlamasına ve kabızlığa neden olabilirken, hipertiroidizm (aşırı aktif tiroid) bağırsak hareketini hızlandırıp ishale neden olabilir.
- Diyabet: Diyabetteki hormonal dengesizlikler bağırsaklardaki sinirleri etkileyebilir ve mide boşalmasının geciktiği diyabetik gastropareziye yol açabilir.
5. Mikrobiyom ve hormonlar
Bağırsak mikrobiyomu aynı zamanda hormonal dengede de rol oynar ve tam tersine hormonlardan etkilenebilir. Örneğin seks hormonları bağırsak florasının bileşimini değiştirebilir ve bu da genel sağlık ve refahı etkileyebilir.
Sonuç
Bağırsak üzerindeki hormonal etki karmaşık ve çok katmanlıdır. Hormonlar farklı seviyelerde etki gösterir ve bağırsak fonksiyonunu ve sağlığını hem doğrudan hem de dolaylı olarak etkileyebilir. Bu ilişkilerin daha iyi anlaşılması, hormonal ve gastrointestinal sağlık sorunlarının etkili bir şekilde tedavi edilmesi için önemlidir.
Muayenehanemde, bireysel yapıyı ve ilgili mizacı belirliyor ve diyet ve tedavileri buna göre uyarlıyorum!
Ve eğer uzakta yaşıyorsanız, konuyu daraltmak için çevrimiçi sağlık danışmanlığını kullanabiliriz.
Bana sormaktan çekinmeyin!

Kaynaklar:
Gastrointestinale Hormone:
- Buchanan, K., & Freeman, S. L. (2003). The role of gut hormones in the regulation of food intake and energy homeostasis. Nutrition Research Reviews, 16(2), 137-149.
- Holst, J. J. (2007). The physiology of glucagon-like peptide 1. Physiological Reviews, 87(4), 1409-1439.
Cinsel hormonlar ve etkisi:
- Bharadwaj, S., Barber, M. D., Grainger, J., & Brown, H. W. (2018). The impact of menopause on the gastrointestinal tract. Journal of the American Medical Association, 319(10), 987-995.
- Parry, S. D., & Barton, J. R. (2000). The influence of the menstrual cycle on gastrointestinal symptoms. European Journal of Gastroenterology & Hepatology, 12(3), 303-307.
Stresshormonlari:
- Mayer, E. A. (2000). The neurobiology of stress and gastrointestinal disease. Gut, 47(6), 861-869.
- Stasi, C., Orlandelli, E., & Milani, S. (2012). Stress and the gut: pathophysiology, clinical consequences, diagnostic approach and therapy. European Journal of Internal Medicine, 23(6), 412-420.
Hormonelle rahatsizliklar ve bagirsak
- Vanderpump, M. P. (2011). The epidemiology of thyroid disease. British Medical Bulletin, 99, 39-51.
- Bytzer, P., Talley, N. J., Leemon, M., Young, L. J., Jones, M. P., & Horowitz, M. (2002). Prevalence of gastrointestinal symptoms associated with diabetes mellitus: a population-based survey of 15,000 adults. Archives of Internal Medicine, 162(12), 1361-1368.
Mikrobiota ve Hormonlar:
- Clarke, G., Stilling, R. M., Kennedy, P. J., Stanton, C., Cryan, J. F., & Dinan, T. G. (2014). Minireview: Gut microbiota: the neglected endocrine organ. Molecular Endocrinology, 28(8), 1221-1238.
- Koren, O., Goodrich, J. K., Cullender, T. C., Spor, A., Laitinen, K., Backhed, H. K., … & Ley, R. E. (2012). Host remodeling of the gut microbiome and metabolic changes during pregnancy. Cell, 150(3), 470-480.

